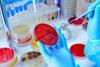
microbiological testing

All Endotoxin articles – Page 2
-
 News
NewsEP monographs allow rFC for water testing
As of 1 April, two European Pharmacopoeia monographs allow the use of rFC to test for bacterial endotoxins in pharmaceutical waters.
-
 Article
ArticleEndotoxin testing: the international regulatory landscape
In this extract from EPR’s Pharma Horizon’s report, Evelyn Der, Lindsey Silva and Carmen Marín Delgado de Robles from Roche Group discuss the regulatory guidelines for bacterial endotoxin testing and the move towards adoption of recombinant methods.
-
Webinar
The trend towards outsourced buffer manufacturing in biopharmaceuticals
Join us as we look at how the outsourcing of buffers is helping biopharma drug manufacturers to streamline their processes.
-
 Whitepaper
WhitepaperApplication Note: Automated Set-Up of the PyroGene® rFC Assay
Automating the pipetting steps of the PyroGene® rFC Assay on the ASSIST PLUS helps to reduce the opportunity for pipetting errors and ensures robust reproducibility.
-
Article
Sustainability in BET from your endotoxin experts
Specialising in chromogenic and turbidimetric reagent technologies, Associates of Cape Cod, Inc. (ACC) has been a global leader in endotoxin and (1→3)-ß-D-glucans detection products and services for nearly 50 years.
-
Whitepaper
Under the microscope: Scientifically sustainable endotoxin testing with Endosafe® Trillium™ recombinant cascade reagent (rCR)
Interested in scientifically sustainable endotoxin testing? Discover more about Endosafe® Trillium™ recombinant cascade reagent (rCR)
-
 Video
VideoVideo: Ami Polymer: Setting new bioprocessing standard
Our dedication to quality and prompt service has earned us several awards. You can trust us for top-notch service and reliability.
-
 Whitepaper
WhitepaperApplication note: Low Endotoxin Recovery case study
This case study discusses the Low Endotoxin Recovery (LER) phenomenon in the drug testing and mitigation approach using the ENDO-RS® kit and ENDOLISA® assay for detecting endotoxin interference
-
Whitepaper
Whitepaper: Changing regulatory environment for nitrosamine impurities
This whitepaper provides an overview of the regulatory challenges posed by the detection of nitrosamine impurities in pharmaceutical products.
-
 News
NewsNovel strategy could facilitate rapid online-endotoxin monitoring
An innovative, chemosensor-based method for detection of lipopolysaccharide (LPS) is set to facilitate development of a rapid online-endotoxin monitor.
-
Whitepaper
Technical document: Introducing: Ami Polymer's Sterile Sampling Systems
Next-Gen Sterile Sampling System: Pinnacle Compliance - USP Standards 87, 88, 85, 661.1, 788, 71, and ISO 11737-1 for Unparalleled Pharma & Biopharma
-
 News
NewsProposed non-animal derived reagent Chapter published
USP’s proposed new Chapter , which offers additional information on Bacterial Endotoxins Tests (BETs) using non-animal derived reagents, has been published as a General Announcement in advance of public consultation.
-
Whitepaper
Whitepaper: Are nitrosamines a concern for biologic manufacturers?
Nitrosamine genotoxins in several pharmaceuticals has led to monitoring of manufacturing practices for products considered at risk.
-
Whitepaper
Whitepaper: Navigating nitrosamine impurity testing
Nitrosamine impurities have become a concern in the bio/pharmaceutical industries, due to their carcinogenic properties and presence in medications.
-
 News
NewsDetermining accurate estimation of true endotoxin concentration
Research suggests that performing LAL gel clot tests and narrowing the dilution range can provide good estimation of endotoxin concentration in pharmaceuticals.
-
 News
NewsISO publishes standard on bacterial endotoxin testing
Evaluation of bacterial endotoxin pyrogens is included in the International Organization for Standardization (ISO)’s new standard for microbiological methods.
-
News
NewsWhy is microbiological testing in medical device manufacturing important?
Careful planning during manufacture means accurate microbiology testing methods can be developed, ensuring the safety and efficacy of medical devices, a paper reports.
-
 Article
ArticleGuide To Testing
In this edition, experts from Institute of Biomedical Research Antoine Marxer and Associates of Cape Cod International share insight on endotoxin testing.
-
 Article
ArticleEuropean Pharmaceutical Review Issue 2 2023
EPR Issue 2 includes articles on the future of cell and gene therapy, the potential of AAV gene therapies, NMR relaxometry and more…
-
Webinar
Controlling endotoxins contamination during pharmaceutical production
Watch this webinar to learn from Peter Cornelis, how to prevent endotoxins contamination during pharmaceutical production, as well as gain insights into sampling plans, test methods, and method optimisation.
- Previous Page
- Page1
- Page2
- Page3
- Next Page



